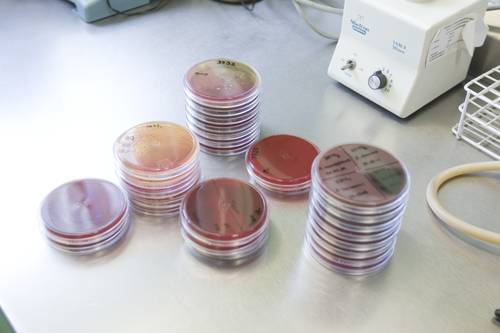
Foto

Sin delimitar aún, el periodo de incubación del A/H1N1: Patricia Volkov
Jueves 7 de mayo de 2009, p. 3
Es un “verdadero problema de salud pública mundial, no solamente con virus, sino también con bacterias”, la resistencia a ciertos medicamentos, lo cual pudo ser un factor que provocó la muerte de personas con influenza A/H1N1, sostuvo Patricia Volkov, infectóloga del Instituto Nacional de Cancerología. También tiene que ver la cantidad de personas que enfermaron, agregó.
Dijo que en dos semanas se verá si la epidemia se controló y que el invierno puede ser un escenario propicio para que rebrote el virus y más agresivamente. “Es difícil que se tenga una vacuna efectiva para la próxima temporada invernal.”
En entrevista agregó que “este escenario nunca lo habíamos vivido: enfrentarnos con un nuevo virus, un número importante de pacientes muy graves, con problemas respiratorios, que aumentaron de manera importante la demanda de atención, no lo habíamos visto en la era moderna, al menos en las pasadas tres décadas. La epidemia no nos tomó sin ninguna preparación de logística, pero no es lo mismo la teoría que la práctica”.
Necesario, continuar con las medidas preventivas
–¿Cuál es la situación de la epidemia en este momento?
–Con las medidas tomadas disminuyó la transmisión del virus, empezó a bajar de manera importante el número de pacientes con cuadro clínico de probable de influenza, pero siguen llegando enfermos graves, aunque en menor cantidad. Hay que continuar con las medidas preventivas; es una oportunidad para educarnos en prevenir enfermedades respiratorias. El problema es que la influenza viene por oleadas y puede regresar; todavía existe un universo de gente muy grande susceptible al virus.
–¿Cuánto tiempo se requiere para saber la evolución de la epidemia?
–Si el periodo de incubación del virus es de entre 24 horas y siete días, que es lo que parece ser en este momento, creo que en 15 días podríamos saber si verdaderamente el brote está controlado.
–¿Qué se desconoce del virus, que sea importante para hacerle frente?
–No tenemos todavía delimitado su periodo de incubación, lo cual es importante. La tasa de ataque. Es necesario tener cuidado, porque muchas pruebas nos dan falsos negativos; hay gente con cuadro clínico que tuvo contacto con un caso, se hace la prueba y sale negativa. Podrían hacerse las dos estimaciones, una con base en casos confirmados mediante pruebas y otra con casos clínicos.
“También se debe llegar a entender la dinámica del virus y su transmisibilidad. Otro factor que debemos conocer del virus es su capacidad para afectar el tejido pulmonar, esto todavía no se ha contestado. Uno de los cuadros que provoca es la ‘tormenta de citoquinas’, igual al SARS, que produce un edema pulmonar agudo que lleva a un síndrome de respuesta de insuficiencia respiratoria; se trata de un proceso inflamatorio tan agresivo que daña el pulmón. Se debe saber si tiene mayor capacidad de despertar esta respuesta o son factores individuales, genéticos de una persona que responde así. Esto ha ocurrido sobre todo en los jóvenes.”
Favorece neumonías bacterianas
–¿Por qué hay más casos de neumonía que en otros años?
–El virus favorece que haya neumonías bacterianas secundarias. Si sólo nos basamos en casos confirmados diremos: es un problema de salud, pero no tan grave. Pero si nos basamos en pacientes con casos clínicos de influenza grave, que han llegado a los hospitales, evidentemente estamos ante un problema muy grave.
–¿Por qué ocurren las muertes en México?
–La eficiencia de transmisión con el número de afectados; tienes más gente enferma que puede desarrollar este cuadro grave. Una ciudad como la nuestra o las grandes urbes donde hay mucho hacinamiento, tiene gente que se enferma. Algunos desarrollaron el virus en tres o cuatro días, no se diagnosticaba como influenza y a los pacientes se le daba el tratamiento que creía correcto. Lo tuvimos personalmente con la amantadina, pero el virus es persistente.

















